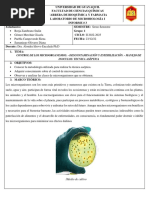

ANTIDIABÉTICOS
Presentado por :
Miguel soler
Danis cortina
� Se usa para tratar los niveles altos de azúcar
METFORMINA 850mg en la sangre ocasionados por la diabetes tipo2.
ayuda a controlar la cantidad de glucosa
(azúcar) en su sangre.
FORMA FARMACÉUTICA:
comprimidos recubiertos con película
POSOLOGIA:
1 comprimido de 850 mg una vez al día,
administrado durante o después de las
comidas.
EFECTOS ADVERSOS:
diarrea, náusea y malestar estomacal.
� se utiliza para tratar la diabetes tipo 1 (afección en
INSULINA GLARGINA la que el cuerpo no produce insulina y, por lo tanto,
no puede controlar la cantidad de azúcar en
sangre).
CONCENTRACION: 100ul/ml
Cada ml contiene 100 unidades de insulina
glargina
POSOLOGIA:
Las dosis habituales de mantenimiento oscilan
entre 0,5 y 1,5 UI/kg/día.
Los requerimientos de insulina son específicos
para cada paciente y varían en función de la edad,
peso corporal.
EFECTOS ADVERSOS:
enrojecimiento, inflamación, dolor o picazón en el sitio de la inyección.
cambios en la textura de su piel.
� Sirve para reducir el azúcar en la sangre hasta
ROSIGLITAZONA 4mg niveles normales y ayuda al organismo a utilizar
mejor la insulina que produce.
FORMA FARMACEUTICA:
comprimidos
POSOLOGIA:
dosis de 4mg al día, se puede
tomar con o sin alimentos.
CONTRAINDICACIONES:
Esta contraindicado para pacientes con
insuficiencia cardiaca.
� sirve para aumentar la producción de insulina
en el cuerpo humano, reduciendo así los
GLIBENCLAMIDA 5mg niveles de azúcar en la sangre en pacientes
que sufren de Diabetes Tipo 2. acompañado de
una dieta y ejercicios.
FORMA FARMACÉUTICA:
Comprimidos blancos, redondos y
ranurados en una de las caras.
POSOLOGIA:
La dosis inicial recomendada es de 2,5 mg a 5
mg al día.
Su dosis máxima es de 15mg al día.
EFECTOS ADVERSOS:
Náusea, vómito, anorexia, diarrea, alteraciones del gusto, cefalea.
� se usa junto con un régimen alimenticio y
ejercicios, y algunas veces junto a otros
SITAGLIPTINA 100mg medicamentos, para tratar los niveles altos de
azúcar en sangre, en adultos con diabetes
tipo 2
FORMA FARMACEUTICA:
Comprimido recubierto con película,
redondo.
POSOLOGÍA:
La dosis es de 100 mg de sitagliptina
una vez al día
� Se utiliza para trata la diabetes tipo 2, ayuda al
REPAGLINIDA 1mg cuerpo a regular la cantidad de glucosa en la
sangre(azúcar) en la sangre.
FORMA FARMACEUTICA:
comprimido
POSOLOGIA:
dosis de 1 o 2 mg antes de cada comida, no se
debe exceder de 16 mg al día.
EFECTOS ADVERSOSOS:
Dolor de cabeza
Congestión nasal
Dolores en las articulaciones.
� INDICACIONES: Tratamientos de
Insulina Humana 100 Ul/mL pacientes para diabetes mellitus que
requieran insulina para el mantenimiento de
la homeostasis de la glucosa
FORMA FARMACEUTICA:
Solucion inyectable
POSOLOGIA:
Diabetes tipo 1: De 0.5-1 UI/kg al día
Diabetes tipo 2: De 0.3-0.6 UI/kg al día
EFECTOS ADVERSOSOS:
Reacciones hipoglucemia.
Cambiar significativamente la dosis
Producir la formación de anticuerpos
� Se utiliza para el tratamiento de la diabetes tipo
GLIMEPIRIDA 2mg II, Cuando la dieta y el ejercicio físico y la
reducción de peso por si solos no son adecuados.
FORMA FARMACEUTICA:
Comprimido
POSOLOGIA:
Tomar 2 mg comprimidos al día, justo antes o con
la primera comida del día.
EFECTOS ADVERSOSOS:
Orina de color oscuro
Diarrea
Fiebre
Dolor de garganta.
� Indicado como monoterapia (cuando el
ACARBOSA 50mg tratamiento dietético es insuficiente)
o en combinación con insulina.
FORMA FARMACEUTICA:
comprimido
POSOLOGIA:
Tomar 1 tableta de 50mg tres veces al día
EFECTOS ADVERSOSOS:
Hinchazón de estomago
Flatulencia
diarrea.
� Se utiliza para trata la diabetes tipo 2 una
condición en la cual el cuerpo no puede usar en
MIGLITOL 50mg forma normal la insulina que produce y como
consecuencia no puede controlar el nivel de
azúcar en la sangre.
FORMA FARMACEUTICA:
comprimido
POSOLOGIA:
Dosis inicial 50mg/8h, que se ajusta
posteriormente según la tolerancia, a lo largo de
4- 12 semanas, hasta una dosis máxima de
100mg/8h
EFECTOS ADVERSOSOS:
Diarrea
Distensión abdominal
� Se utiliza para trata la diabetes tipo 2, no
DULAGLUTIDA 1.5mg /0.5 ml suficientemente controlada a dieta y ejercicio.
FORMA FARMACEUTICA:
ampolla
POSOLOGIA:
Se administra una vez a la semana sin tomar en
cuenta las comidas
EFECTOS ADVERSOSOS:
Disminución del apetito
Estreñimiento
Fatiga
vomito.
�EMPAGLIFLOZINA Se utiliza para reducir el azúcar en la sangre
haciendo que los riñones eliminen mas glucosa en
10mg la orina.
FORMA FARMACEUTICA:
comprimido
POSOLOGIA:
10 mg una vez al día.
EFECTOS ADVERSOSOS:
sarpullido
Uurticaria
Picazón
�GRACIAS